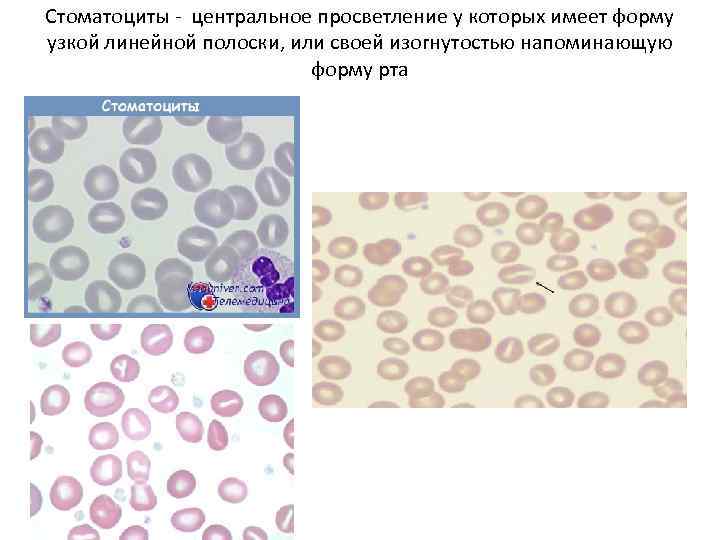
Стоматоциты - центральное просветление у которых имеет форму узкой линейной полоски, или своей изогнутостью
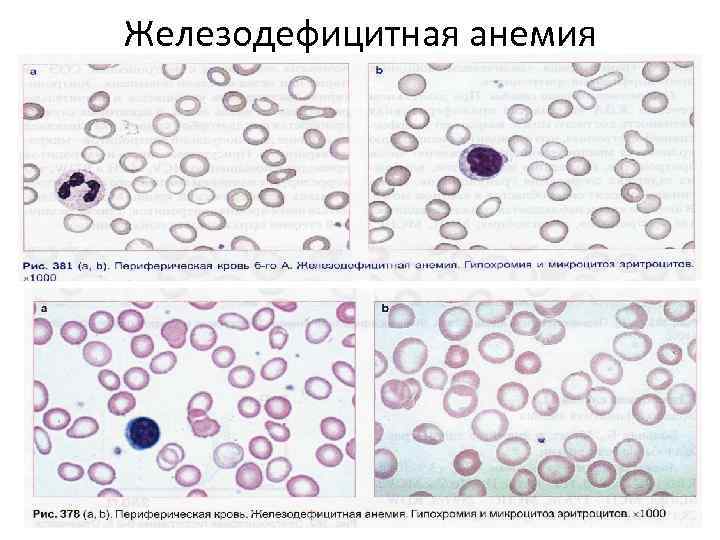
Железодефицитная анемия
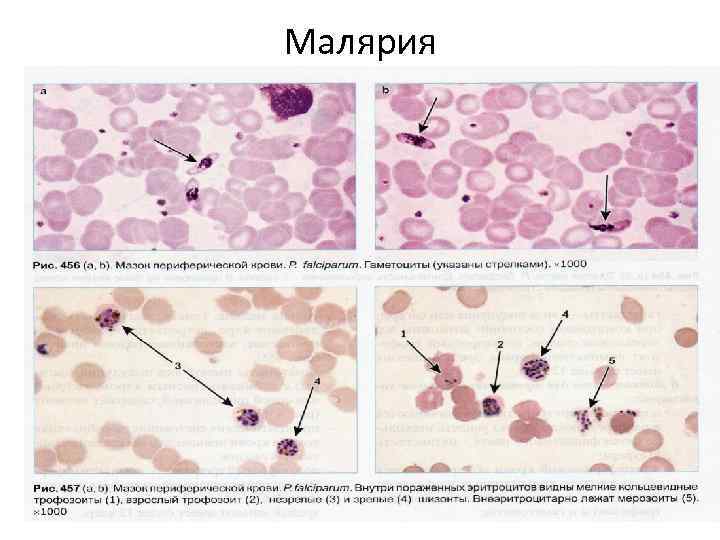
Малярия

Презентация Microsoft Office PowerPoint 2003.ppt
- Количество слайдов: 57
 Гематология Лысова В. А.
Гематология Лысова В. А.
 Гемопоэз
Гемопоэз

 Миелопоэз
Миелопоэз
 Эритропоэз
Эритропоэз
 Моноцитопоэз
Моноцитопоэз
 Зрелые клетки крови
Зрелые клетки крови
 Лимфоциты
Лимфоциты


 Тромбоцитопоэз
Тромбоцитопоэз
 Мегакариобласт и мегакариоцит в цитоплазме тромбоциты.
Мегакариобласт и мегакариоцит в цитоплазме тромбоциты.
 Нормобласты
Нормобласты
 Ретикулоциты
Ретикулоциты
 Варианты эритроцитов
Варианты эритроцитов
 Гистограммы эритроцитов
Гистограммы эритроцитов
 СФЕРОЦИТЫ – ОТСУТСТВУЕТ ЦЕНТРАЛЬНОЕ ПРОСВЕТЛЕНИЕ, ПРИ НАСЛЕДСТВЕННЫХ ДЕФЕКТАХ МЕМБРАНЫ ЭРИТРОЦИТОВ.
СФЕРОЦИТЫ – ОТСУТСТВУЕТ ЦЕНТРАЛЬНОЕ ПРОСВЕТЛЕНИЕ, ПРИ НАСЛЕДСТВЕННЫХ ДЕФЕКТАХ МЕМБРАНЫ ЭРИТРОЦИТОВ.
 Эритроциты овальной формы при наследственном овалоцитозе, при тяжёлых жда, лейкозах, мегалобластных анемиях
Эритроциты овальной формы при наследственном овалоцитозе, при тяжёлых жда, лейкозах, мегалобластных анемиях
 Мишеневидные эритроциты с центральным скоплением гемоглобина
Мишеневидные эритроциты с центральным скоплением гемоглобина
Стоматоциты - центральное просветление у которых имеет форму узкой линейной полоски, или своей изогнутостью напоминающую форму рта
Стоматоциты - центральное просветление у которых имеет форму узкой линейной полоски, или своей изогнутостью напоминающую форму рта
 Акантоциты – эритроциты зубчатой формы, при наследственном акантоцитозе, при заболевании печени, после спленэктомии, при нарушении обмена липидов.
Акантоциты – эритроциты зубчатой формы, при наследственном акантоцитозе, при заболевании печени, после спленэктомии, при нарушении обмена липидов.
 Эхиноциты
Эхиноциты
 Серповидные эритроциты при серповидно-клеточной анемии и шизоциты
Серповидные эритроциты при серповидно-клеточной анемии и шизоциты
Железодефицитная анемия
Железодефицитная анемия
 Костный мозг при апластической анемии
Костный мозг при апластической анемии
 Базофильная пунктация, кольца Кебота, тельца Жолли в полихроматофильном эритроците, мегалоциты
Базофильная пунктация, кольца Кебота, тельца Жолли в полихроматофильном эритроците, мегалоциты
 Базофильная пунктация, тельца Жолли, гиперсегментация нейтрофила при В 12 дефицитной анемии
Базофильная пунктация, тельца Жолли, гиперсегментация нейтрофила при В 12 дефицитной анемии
 Дегенеративные изменения нейтрофилов
Дегенеративные изменения нейтрофилов


 Кариорексис, тельца Деле, вакуолизация в нейтрофилах
Кариорексис, тельца Деле, вакуолизация в нейтрофилах
 Гиперсегментация, вакуолизация, псвдопельгеризация, токсогенная зернистость
Гиперсегментация, вакуолизация, псвдопельгеризация, токсогенная зернистость
 Пельгеровская аномалия нейтрофилов
Пельгеровская аномалия нейтрофилов
 Лейкемоидные реакции лимфоидного типаинфекционный мононуклеоз
Лейкемоидные реакции лимфоидного типаинфекционный мононуклеоз
 Вирус Эпштейн – Барра. Инфекционный мононуклеоз. Вирус поражает лимфоидную ткань – Т и В – лимфоциты. Лимфоаденопатия, увеличение печени и селезёнки, тонзилит, появление в крови мононуклеаров, сыпь.
Вирус Эпштейн – Барра. Инфекционный мононуклеоз. Вирус поражает лимфоидную ткань – Т и В – лимфоциты. Лимфоаденопатия, увеличение печени и селезёнки, тонзилит, появление в крови мононуклеаров, сыпь.
 Лейкемоидные реакции: нейтроофильного, эозинофильного и моноцитарного типа
Лейкемоидные реакции: нейтроофильного, эозинофильного и моноцитарного типа
 Плазматические клетки конечный этап развития В – ЛИМФОЦИТОВ.
Плазматические клетки конечный этап развития В – ЛИМФОЦИТОВ.

 Лейкозы
Лейкозы
 Острый миеломонобластный лейкоз М 4, монобластный лейкоз М 5 и М 6
Острый миеломонобластный лейкоз М 4, монобластный лейкоз М 5 и М 6
 Острый эритромиелоз М 6 и острый мегакариоцитарный лейкоз М 7
Острый эритромиелоз М 6 и острый мегакариоцитарный лейкоз М 7
 Острые лимфобластные лейкозы L 1, L 2
Острые лимфобластные лейкозы L 1, L 2
 Острый лимфобластный лейкоз L 3,
Острый лимфобластный лейкоз L 3,
 Хронические лейкозы ХМЛ хроническая фаза
Хронические лейкозы ХМЛ хроническая фаза
 ХМЛ ФАЗА АКСЕЛЕРАЦИИ И БЛАСТНЫЙ КРИЗ
ХМЛ ФАЗА АКСЕЛЕРАЦИИ И БЛАСТНЫЙ КРИЗ
 Хронический моноцитарный лейкоз, и хронический миеломоноцитарный лейкоз
Хронический моноцитарный лейкоз, и хронический миеломоноцитарный лейкоз
 Хронический лимфолейкоз
Хронический лимфолейкоз
 Хронический пролимфоцитарный лейкоз
Хронический пролимфоцитарный лейкоз
 Волосатоклеточный лейкоз, миеломная болезнь или плазмоцитома
Волосатоклеточный лейкоз, миеломная болезнь или плазмоцитома
 Миеломная болезнь. Плазматические клетки с тельцами Рассела в чядре и цитоплазме.
Миеломная болезнь. Плазматические клетки с тельцами Рассела в чядре и цитоплазме.
 Т- клеточная лимфома. Клетки Сезари – лимфоциты с неправильной формой ядер, мозговидной структурой хроматина.
Т- клеточная лимфома. Клетки Сезари – лимфоциты с неправильной формой ядер, мозговидной структурой хроматина.
 Клетка Березовского – Штербберга – Рид при ЛИМФОГРАНУЛОМАТОЗЕ.
Клетка Березовского – Штербберга – Рид при ЛИМФОГРАНУЛОМАТОЗЕ.
 Клетки красной волчанки
Клетки красной волчанки
 Кровепаразиты кольцевые трофозоиты и лейшмании
Кровепаразиты кольцевые трофозоиты и лейшмании
Малярия
Малярия
 Трипаносомы и спирохеты
Трипаносомы и спирохеты
 СПАСИБО ЗА ВНИМАНИЕ !
СПАСИБО ЗА ВНИМАНИЕ !


